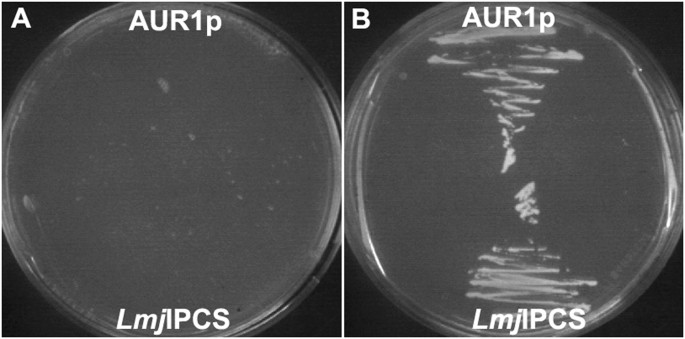
figure 1

Abstract
Leishmaniasis is a Neglected Tropical Disease caused by the insect-vector borne protozoan parasite, Leishmania species. Infection affects millions of the world’s poorest, however vaccines are absent and drug therapy limited. Recently, public-private partnerships have developed to identify new modes of controlling leishmaniasis. Drug discovery is a significant part of these efforts and here we describe the development and utilization of a novel assay to identify antiprotozoal inhibitors of the Leishmania enzyme, inositol phosphorylceramide (IPC) synthase. IPC synthase is a membrane-bound protein with multiple transmembrane domains, meaning that a conventional in vitro assay using purified protein in solution is highly challenging. Therefore, we utilized Saccharomyces cerevisiae as a vehicle to facilitate ultra-high throughput screening of 1.8 million compounds. Antileishmanial benzazepanes were identified and shown to inhibit the enzyme at nanomolar concentrations. Further chemistry produced a benzazepane that demonstrated potent and specific inhibition of IPC synthase in the Leishmania cell.
Similar content being viewed by others
Introduction
The Neglected Tropical Disease (NTD) leishmaniasis is endemic in over 90 countries worldwide, affecting approximately 12 million people per year with 350 million people living at risk of disease. The causative agent, Leishmania species, are sandfly borne kinetoplastid protozoan parasites1.
A vaccine to prevent leishmaniasis is not currently available and treatment relies entirely on a limited number of chemotherapeutics with, in the most part, unclear modes of action2. For example, cutaneous leishmaniasis (CL, e.g. caused by L. major) therapy largely relies on two pentavalent antimonials, sodium stibogluconate (Pentostam) and meglumine antimoniate (Glucantime)3,4. Despite their problems, including severe side-effects such as cardiotoxicity and the requirement for parenteral administration5, Pentostam and Glucantime have been in clinical use for more than 70 years6. The treatment options for visceral leishmaniasis (VL, Kala-Azar; largely caused by L. donovani) suffer from similar problems, with antimonial therapy still widely employed3,4. In addition, resistance to these drugs is rising and threatening their continued use in the treatment of leishmaniasis7. Amphotericin B (Fungizone) has also been used in the treatment of both CL and VL8. However, this is also associated with severe side-effects, and must be administered parentally9. Miltefosine, is the only orally available antileishmanial and has been used to treat VL in India since 2002, however, this antineoplastic compound also exhibits teratogenicity and resistance is increasingly apparent10. Therefore, the current elimination programme in South Asia relies upon liposomal amphotericin B administered as a single injection. However, whilst effective and less toxic than the non-liposomal formulation, treatment failure and post-Kala-Azar dermal leishmaniasis (PKDL) may preclude elimination11.
With these severe problems in the treatment and control of both CL and VL, it is recognized that new antileishmanial targets and drugs need to be identified. High throughput screening (HTS) is a vital component of drug discovery and can be carried out using either in vitro assays against validated targets or in phenotypic assays against the parasite itself12,13. Recent high content phenotypic screening across the pathogenic kinetoplastids gave a disappointingly low number of novel potent hits against Leishmania donovani when compared with the related parasites Trypanosoma brucei and T. cruzi14. This demonstrated the importance of target-based screening for antileishmanial discovery to access to novel chemical space and new modes of action which may overcome resistance and be compatible in combination therapies.
In contrast to mammalian cells, where the predominant complex sphingolipid is sphingomyelin (SM), fungi, plants and some protozoa synthesize inositol phosphorylceramide (IPC)15,16. The fungal IPC synthase (AUR1p) has long been established as a drug target for pathogenic fungi17. Similarly, the Leishmania orthologue, and those from the pathogenic Trypanosoma species, have been suggested to be ideal, non-mammalian, targets for the development of new, less toxic, antiprotozoals15,18,19,20. Furthermore, systems biology studies have reinforced the status of the Leishmania enzyme as a putative target for drug discovery programmes21. However, as an integral membrane protein with 6 transmembrane domains, and lipid substrates (phosphatidylinositol and ceramide) and products (diacylglycerol and IPC), formatting the Leishmania IPC synthase into a conventional in vitro assay platform is challenging22. Therefore, utilizing the ability of the kinetoplastid enzyme to complement for the absence of the Saccharomyces cerevisiae orthologue AUR1p23, here we describe the development and formatting of a robust yeast-based ultra-HTS (uHTS) assay platform. This was then utilized, in the largest effort of its type, to screen a high content (1.8 M) compound library for specific Leishmania IPC synthase inhibitors. 500 potent and specific such compounds were identified; these were then reduced to 211 following clustering to remove structural replicates. Following screening against mammalian-stage axenic amastigote L. donovani, 25 of these compounds were selected on the basis of potency, selectivity and physicochemical properties. These hits were then reduced to five following further screening of L. donovani infected macrophages. From these, one pair of structurally related compounds, the benzazepanes, was selected for further analyses. Importantly, these compounds demonstrated sub micro-molar activity against the enzyme target in a secondary in vitro assay and selectivity for the enzyme in cellulo when using an available L. major sphingolipid mutant24. This work demonstrated the tractability of yeast-vehicles for uHTS, with the identification of the benzazepanes as potential antileishmanials with specific inhibitory activity against IPC synthase.
Results
Design and validation of a robust Leishmania IPC synthase assay for uHTS
HTS campaigns predominantly rely on two approaches: (i) in vitro target-directed screening using biochemical assays; (ii) cell-based phenotypic screening which takes no account of the target. Both of these approaches have significant limitations, such as the production of soluble protein and a lack of cellular context for biochemical assays, and the problems of process redundancy in cells used for phenotypic screening13. Furthermore, both can be difficult to miniaturize and expensive to utilize for uHTS. With these problems in mind, yeast-based systems have been utilized to provide cost-effective, target-directed, screening platforms for protein targets within a eukaryotic cellular context13. Recently, this approach has been adopted for antiprotozoal drug discovery12,25,26.
The transmembrane nature of the target Leishmania IPC synthase, and the hydrophobicity of the lipid substrates and products, rendered it challenging to develop a uHTS biochemical assay18,19,22. However, given that the enzyme has been shown to complement an auxotrophic Saccharomyces cerevisiae mutant18 the development of yeast-based screening platform was considered tractable. To develop a robust assay suitable for uHTS, rather than the previously utilized auxotrophic mutant18, a strain of S. cerevisiae completely lacking the yeast IPC synthase, AUR1p, was selected as the vehicle (a kind gift from Teresa Dunn, Uniformed Services University)27. This strain is reliant on the expression of essential AUR1p from a uracil selectable expression plasmid (pRS316-URA-AUR1)27. Transforming these with the plasmid pESC-LEU (Agilent) harbouring the L. major IPC synthase (LmjFIPCS) or AUR1p under the control of a galactose promotor, allowed for curing the yeast of pRS316-URA-AUR1 using the pyrimidine analogue 5-fluoro-orotic acid (5-FOA) and the selection of a strain dependant on the galactose inducible expression of LmjFIPCS (Fig. 1). The yeast dependant on either LmjFIPCS or AUR1p expression were then used to format an LmjFIPCS assay suitable for uHTS.
Generation of yeast strains for uHTS assay. Yeast lacking AUR1p completed by galactose dependent expression of AUR1p (α ade−.lys−.leu−.Δaur1−.pESC-LEU_AUR1) or LmjFIPCS (α ade−.lys−.leu−.Δaur1−.pESC-LEU_LmjFIPCS) grown on selective media with either glucose (A) or galactose (B). Expression of both AUR1p and LmjFIPCS rescues growth of the mutant S. cerevisiae.
Exploiting the fact that growing yeast secretes exo-β-glucanase, which, as well as modifying the cell wall, can also hydrolyse non-fluorescent fluorescein di-(β-D-glucopyranoside) (FDGlu) to release fluorescein, an assay was developed in which cell growth was monitored by fluorescent output28. The optimal concentrations of galactose (0.1%), starter culture (OD600 0.063) and FDGlu (10 μM) were established in 96- and 384-well formats incubated at 30 °C for 24 hours. The assay was then miniaturized into a 1536-well format, the most appropriate positive control (cycloheximide) selected and the robustness of the platform indicated by Z’ values >0.529. Screening using a GSK standard set of (9766) compounds further validated the assay, established inhibition threshold values and indicated a hit-rate of 1.07%.
Identification of selective and potent inhibitors
Taking the robust 1536-well format assay developed, a primary uHTS screening was conducted using the 1.8 million compound GSK library against the LmjFIPCS dependent yeast. Given the hit-rate of 1.07% with the standard set approximately 19000 hits were anticipated. Initially this expectation was not reached, however reducing the inhibition threshold to capture small (≤300 Da molecular weight), polar (cLogP ≤ 3) ‘drug-like’ compounds with lower efficacy, led to the identification of 19669 hits. The mean Z’ for the screen was 0.70, demonstrating the platform to be robust.
At this stage, the primary screen, it was unclear whether the hit compounds inhibited the LmjFIPCS enzyme or (an)other essential process(es) within the yeast vehicle. Therefore, a counter screen was performed against the yeast dependant on AUR1p expression at a single compound concentration of 10 μM. In parallel, a confirmatory screen against the LmjFIPCS dependent yeast was performed at the same concentration. After calculation of the inhibition thresholds for each strain, those compounds demonstrating activity above the LmjFIPCS threshold but below AUR1p threshold were selected. In addition, to avoid loss of highly potent compounds, those demonstrating >80% inhibition of the LmjFIPCS dependent yeast were retained whatever the response against AUR1p dependent yeast.
As a result of this process, 4166 compounds were progressed further for dose response analyses. Using the optimized assay conditions, these compounds were screened against the yeast dependant on either LmjFIPCS or AUR1p expression at 11 concentrations between 100 μM to 1.7 nM. From these data, the −logIC50 (pIC50) molar unit values of each compound were calculated against each strain and the data plotted (Fig. 2). This allowed analyses of both potency and selectivity, with 500 compounds demonstrating potent activity against LmjFIPCS dependant yeast, pIC50 ≥ 5 (IC50 ≤ 10 μM), and good selectivity when compared to AUR1p dependant yeast, pSI ≥ 1.5 (logSI [pIC50 LmjFIPCS - pIC50 AUR1], where SI is Selectivity Index). This represented a hit rate of 0.0063% for the identification of potent and selective hits against LmjFIPCS.
The dose response (−logIC50 M [pIC50]) of the initially identified 4166 selective hit compounds. Yeast dependent on Leishmania IPC synthase activity (LmjFIPCS) against yeast dependent on AUR1p expression. The inset shows the colour key for compound selectivity (logSI [pSI] where SI is Selectivity Index). 500 hits with a pSI > 1.50 were selected for further analyses (orange, turquoise and brown).
These 500 compounds were subsequently clustered using a sphere exclusion algorithm30. Briefly, a fingerprint for each hit was compared to every other molecule in the set and compounds demonstrating significant similarity ( > 0.85 on a scale of 0–1) were sorted into clusters. Two representatives from each cluster plus all singletons, 211 compounds, were taken forward for further analyses.
Cell-based screening of identified compounds
To establish the antileishmanial activity of the 211 selected hits, they were screened against L. donovani axenic amastigotes (the mammalian, pathogenic form) in a dose response assay with 11 compound concentrations between 50 μM and 0.85 nM. The data revealed 70 compounds with a calculated pIC50 ≥ 5 (IC50 ≤ 10 μM; Fig. 3A; SI Table).
The triage of 211 clustered hits. (A) Dose response against axenic Leishmania donovani amastigotes, −logIC50 M (pIC50) ≥5 selected (70 active compounds; on or above green line); (B) Comparison of dose response values from (A) versus the 70 compounds selectivity (logSI [pSI] where SI is Selectivity Index) against human HepG2 cells, pSI ≥1 selected (49 non-toxic compounds; on or above green line); (C) Predicted Property Forecast Index31 (PFI) of these compounds against the number of aromatic rings, PFI ≤ 8 and aromatic rings ≤ 4 selected (25 small/hydrophobic compounds; on or within green lines); (D) Comparison of dose response values of these 25 compounds for intra-macrophage Leishmania donovani amastigotes (InMac) versus the selectivity (pSI) against human THP-1 macrophages, the host, pSI ≥ 1 selected (5 selective compounds; on or within green lines).
Following a screen against HepG2 cells for mammalian cytotoxicity (11 compound concentrations between 100 μM and 1.7 nM), comparing these data with that for the 70 Leishmania hits allowed identification of selective antileishmanial compounds with pSI ≥ 1 (SI ≥ 10); 49 compounds fulfilled these criteria (Fig. 3B). Following a further screen based on the predicted physicochemical properties of these 49 compounds, those compounds showing a Property Forecast Index31 (PFI) ≤8 and ≤4 aromatic rings were selected (Fig. 3C; SI Table 1)). These 25 compounds have relatively low molecular weights and high levels of hydrophilicity indicating they are likely to be soluble and favourable for development, and therefore were progressed to screening against L. donovani infected THP-1 macrophages, the truest representation of the pathogenic state available in vitro. The 25 compounds were screened in a dose response assay with 11 compound concentrations between 50 μM and 0.85 nM. Given the additional membrane barriers the compounds must cross to reach the intra-macrophage amastigotes, the fact that only 7 (out of 25) were completely ineffective while 10 of the remaining 18 active hits demonstrated activity at pIC50 ≥ 5 (IC50 ≤ 10 μM) was promising. Of these 10, 4 had a pSI with respect to the activity against THP-1 macrophages of ≥1 (Fig. 3D; SI Table 1), another had a pSI of 0.99 and was also retained. Of these 5 hits (Fig. 4), the benzazepane compounds (1 and 2) were both active in the low μM range against intra-macrophage amastigotes, pIC50 5.5 and 5.7 respectively. The dithiophene compounds (3 and 4) exhibited similar levels of activity, pIC50 5.7 and 5.9 respectively, however, the presence of the nitro group in this class was a concern given the link with toxicity issues32. Similarly, the singleton (5) possesses a nitro group. In light of the above, the benzazepanes were taken forward for further analyses in a secondary screening platform19,22.
Verification of the benzazepane mode of action
Utilizing the availability of an in-house designed and validated biochemical assay for LmjFIPCS19,22, following re-synthesis in the free-base form (Aptuit, Verona, Italy) the two benzazepane hits were biochemically analyzed in a dose response assay (8 compound concentrations between 100 μM and 46 nM; Fig. 5). Whilst compound 2 was a modest inhibitor of LmjFIPCS (pIC50 5.2), compound 1 was a potent, sub μM, inhibitor of the enzyme (pIC50 6.8).
However, whilst compound 1 was antiprotozoal and a potent IPC synthase inhibitor, it was unclear whether the mode of action was on-target. To analyze this further, the in-house availability of a sphingolipid mutant L. major (Δlcb2) was exploited. This line24 lacks serine palmitoyltransferase activity, and whilst LmjFIPCS is still present it is redundant in the absence of in situ substrate. Therefore, specific inhibitors of LmjFIPCS should be inactive against L. major Δlcb2. However, in a dose response assay, compound 1 demonstrated no significant difference in activity against both lines of L. major (pIC50 5.5 for wild type and Δlcb2: SI Fig. 1)). Therefore, it is likely that off-target activity has a role in the antileishmanial activity of this benzazepane.
Further synthetic efforts (Aptuit, Verona, Italy) led to the synthesis of compounds bearing the left-hand side of 1 and the right-hand side of 2 (compound 6) and vice versa (compound 7; Fig. 6A). Compound 6 lost activity against LmjFIPCS in the in vitro assay; however, compound 7 maintained a pIC50 7.2; although it did not achieve greater than approximately 60% inhibition even at higher concentrations (Fig. 6B). In addition, and importantly, compound 7 demonstrated selectivity for L. major wild type over the Δlcb2 mutant (pIC50 5.5 versus <5; Fig. 6C). The selectivity of compound 7 for the wild type parasite over a line with a redundant LmjFIPCS (Δlcb2), strongly supported a target-directed mode of action. Furthermore, compound 7 demonstrated considerably greater in cellulo inhibition of IPC synthase activity than compound 1, as determined by incorporation of BODIPY® FL C5-ceramide into IPC in the presence of the compounds (Fig. 7). Unfortunately, activity against intramacrophage L. donovani was lost, possibly due to a lack of compound transport to the site of action or intramacrophage stability. However, these data demonstrated that the efficacy of compound 7 against L. major is on-target inhibition of IPC synthase, thus supporting the status of LmjFIPCS as a drug target like its orthologues in the related trypanosomatid pathogen, T. brucei20.
The discovery of a selective inhibitor. (A) Synthesized chimeric compounds 6 and 7; (B) activity of compound 7 against LmjFIPCS in vitro (−logIC50 M [pIC50] 7.2; 95% CI: 7.8–6.9); (C) activity of compound 7 against wild type Leishmania major (red; pIC50 5.5; 95% CI: 5.8–5.2) and the mutant, ΔLCB2 (blue; pIC50 < 5). Values are from at least 3 independent experiments.
In cellulo activity against LmjFIPCS. Compound 7 demonstrated a greater activity against in cellulo LmjFIPCS than compound 1. L. major ΔLCB2 treated with 10 μM of compound prior to metabolic labelling with BODIPY FL C5-ceramide. Inhibition of the incorporation of label into IPC was measured following HPTLC in comparison with a control (vehicle treated). Values are from 3 independent experiments. P = 0.006 in students’ t-test indicating the difference is significant (**≤ 0.01).
Discussion
The identification of leads for the discovery of new drugs for the Neglected Tropical Disease leishmaniasis is a recognized priority2,6. To achieve this aim the development of strong industry-academia partnerships, bridging chemistry and biology, is vital23. Much of such collaborative efforts have employed HTS to identify antiprotozoal compounds, however high content phenotypic screening has produced a poor return of hits against Leishmania spp when compared with the related Trypanosoma spp14. This demonstrated the central importance of target-based screening for the discovery of novel antileishmanial hits which represent new chemical entities with new modes of action.
The Leishmania IPC synthase has been previously identified as a putative drug target18,21, and more recent work has employed a modelling approach to identify coumarin derivatives as enzyme inhibitors with in vivo antileishmanial activity33,34. To search for new classes of Leishmania IPC synthase inhibitors, in a multidisciplinary public-private partnership, we developed a novel yeast-based assay to screen the 1.8 million entity GSK compound library against the protozoan enzyme. To the best of our knowledge, this work reports the largest yeast-based, target-directed assay undertaken to date against targets from any disease state.
5 non-toxic, antileishmanial compounds were identified (a hit rate of 0.00028%), 2 pairs and one singleton. On the basis of a lack of nitro groups the benzazepanes (compounds 1 and 2) were selected to take forward. Both of these demonstrated sub μM activity against axenic L. donovani amastigotes (pIC50, 7.6 and 6.4 for compounds 1 and 2 respectively; SI Table), and low μM activity against L. donovani infected macrophages (pIC50, 5.5 and 5.7 for compounds 1 and 2 respectively; SI Table). The activity of these compounds in cell based assays, when compared to other recently predicted Leishmania IPC synthase inhibitors33,34, was promising. These activity levels were similar to those seen for miltefosine, the only oral therapy for leishmaniasis but with an unclear mode of action2,35. However, they were one or 2 orders of magnitude lower than those for amphotericin B, which functions through selective sterol binding2,35.
Importantly, both benzazepanes demonstrated activity against the Leishmania IPC synthase in vitro, with compound 1 particularly potent (pIC50 6.8). Despite these promising findings, this compound also demonstrated off-target activities in the parasite ( SI Fig.1). However, using a simple ‘mix and match’ approach a benzazepane was identified that had enhanced potency against the enzyme in vitro (pIC50 7.2) and in cellulo (Fig. 7) and demonstrated more selective, on-target antileishmanial activity (Fig. 6).
In summary, this research demonstrated the tractability of yeast-based uHTS to identify inhibitors of challenging, membranous targets such as IPC synthase, which are on-target and specific. Furthermore, the benzazepanes identified represent a new class of antileishmanial compounds with a new mode of action. Further development of these may lead to novel therapies for the Neglected Tropical Disease, leishmaniasis.
Methods
Yeast cell assay
The complete open reading frames of LmjFIPCS and AUR1p was amplified from genomic DNA using Phusion Flash PCR master mix (ThermoFisher) according to manufacturer’s guidelines. Primers were for T4 ligation of LmjFIPCS (F_BamHI cgcggatccATGACGAGTCACGTGACAGC and R_HindIII cccaagcttTTAGTGCTCAGGCAAAGCCGCCG) and In-Fusion cloning (Clontech) of AUR1 (F ctcactatagggcccATGGCAAACC and R tccatgtcgacgcccTTAAGCCCTC). The open reading frames were subsequently cloned into the pESC-LEU vector (Agilent) and verified by sequence analyses, creating pESC-LEU_ LmjFIPCS and pESC-LEU_AUR1. In this vector, expression of the open reading frame was under the control of a galactose promoter. pESC-LEU_ LmjFIPCS and pESC-LEU_AUR1 were subsequently transformed into S. cerevisiae strain α ade−.lys−.leu−.Δaur1−.pRS316.URA+.ScAUR1+27 as previously described18,19,20 and selected on SD -TRP -URA -LEU agar (0·17% Bacto Yeast Nitrogen Base, 0·5% ammonium sulphate, 2% glucose, containing the appropriate nutritional supplements) at 30 °C. Clones were then ‘cured’ of the pRS316-URA plasmid by selection on SGR -TRP –LEU +FOA agar (0·17% Bacto Yeast Nitrogen Base, 0·5% ammonium sulphate, 0.1% galactose, 1% raffinose, 0.1% 5-Fluoroorotic Acid Monohydrate (FOA) containing the appropriate nutritional supplements) at 30 °C, creating α ade−.lys−.leu−.Δaur1−.pESC-LEU_LmjFIPCS and α ade−.lys−.leu−.Δaur1−.pESC-LEU_AUR1. Following validation by PCR and propagation in SGR -TRP –LEU, frozen stocks of both yeast lines were created (OD600 = 10). 10 µM FDGlu and α ade−.lys−.leu−.Δaur1−.pESC-LEU_LmjFIPCS or α ade−.lys−.leu−.Δaur1−.pESC-LEU_AUR1 (defrosted on ice) at OD600 = 0.0625 in SGR -TRP -LEU were prepared and dispensed into 1536-well plates (5 µl per well; ThermoFisher) with appropriate concentrations of compound and controls (vehicle or 1 mM cycloheximide). Volumes were dispensed using a Multidrop Combi Reagent Dispenser, a Multidrop Combi nL or a Labcyte Echo® liquid handler (ThermoFisher). Plates were then incubated, in duplicate, at 30 °C for 25 hours prior to the addition of phosphate buffer (0.25 M, pH 7.0, 5 µl per well) and fluorescence was read at Ex480/Em540 using a ViewLux ultraHTS Microplate Imager (PerkinElmer). Data were analyzed using GSK-developed Statistical Online Data Analysis Software (SODA) and ActivityBase (IDBS).
Leishmania axenic cell assays
As previously described36, L. donovani (MHOM/SD/62/1S-CL2D, LdBOB) axenic amastigotes in growth medium (6 µl) were added to a final concentration of 5.0 × 103 ml−1 with compounds and controls (vehicle and assay media alone, with the robustness of the platform indicated by Z’ values > 0.5)29 in 1536-well plates (Greiner Bio-One FLUOTRAC). The plates, in at least triplicate, were incubated at 37 °C for 72 hours under 5% CO2. Resazurin solution was added, the plates were incubated at room temperature for 4 hours and then the fluorescence read at Ex528/Em590, using an EnVision Multilabel plate reader (PerkinElmer). Volumes were dispensed and data analyzed as above.
From a previously described protocol22, L. major (MHOM/IL/81/Friedlin, wild type and ΔLCB2 mutant)24 were added to 96-well plates (Corning) at 1 × 104 ml−1 in growth media with appropriate concentrations of compounds and controls (vehicle and assay media alone, with the robustness of the platform indicated by Z’ values > 0.5)29 in 100 µl. Following incubation at 26 °C for 72 hours, alamarBlue (ThermoFisher) was added, the plates were incubated at 26 °C for 4 or 8 hours and fluorescence was read at Ex540/Em600, using a FLx800 Fluorescence Microplate Reader and Gen5 1.08 Data Analysis Software (BioTek). Analyses were carried out using GraphPad Prism 7.
Mammalian cell assay
HepG2 cells in media were added (25 µl) at final concentration of 1.2 × 105 ml−1 to 384-well plates (Greiner Bio-One FLUOTRAC) and incubated with compounds and controls (vehicle and cycloheximide) at 37 °C for 48 hours under 5% CO2 and at 80% relative humidity. The plates, in at least duplicate, were incubated at room temperature for 30 minutes prior to the addition of CellTiter-Glo (Promega), followed by incubation at room temperature for 10 minutes and measurement of the luminescent output using a ViewLux ultraHTS Microplate Imager (PerkinElmer). Volumes were dispensed using a Multidrop Combi Reagent Dispenser, a Multidrop Combi nL or a Labcyte Echo liquid handler (ThermoFisher). Data were analyzed using GSK-developed Statistical Online Data Analysis Software (SODA) and ActivityBase (IDBS).
Intramacrophage Leishmania donovani assay
This protocol was based on that previously described36. In brief, THP-1 (human monocytic leukemia) at 6 × 105 ml−1 were infected with eGFP expressing L. donovani LdBOB amastigotes at 6.0 × 106 ml−1 and incubated overnight at 37 °C. Following washing, infected cells were trypsinized and harvested before dispensation into a sterile 384-well plate, at 6.0 × 104 ml−1 in 50 µl post-differentiation growth medium with compounds and controls (vehicle and amphotericin B, with the robustness of the platform indicated by Z’ values > 0.5)29. The plates, in at least duplicate, were incubated at 37 °C for 96 hours under 5% CO2. After fixation with 4% (v/v) formaldehyde in PBS at room temperature for 30 minutes and washing, cells were stained with DAPI (Sigma-Aldrich) at room temperature for 30 minutes, washed, and imaged at Ex405/Em460 and Ex488/Em509 using the Opera® High Content Screening System (PerkinElmer). Volumes were dispensed as above. Images were analyzed using the automated Acapella High Content Imaging and Analysis Software (PerkinElmer).
Biochemical assay
Microsomal material was prepared and CHAPS washed from α ade−.lys−.leu−.Δaur1−.pESC-LEU_ LmjFIPCS as previously described19,22. Briefly, each compound at the desired concentration was incubated, in at least triplicate, in 96-well plates (Corning) in phosphate buffer (71.4 mM, pH 7.0) with PI (100 µM, final concentration, Avanti Polar Lipids), CHAPS (600 µM, Sigma-Aldrich) and CHAPS-washed microsomal membranes (0.6 U enzyme per reaction) for 15 minutes at 30 °C. NBD-C6-ceramide (5 µM; ThermoFisher) was added, final volume of 40 µl per well, and the plates incubated at 30 °C for a further 25 minutes. Following quenching with 200 µl methanol per well, the reaction product was separated using exchange chromatography in 96-well filter plates (Millipore)19,22 and the fluorescence measured at Ex460/Em540 using a FLx800 Fluorescence Microplate Reader and Gen5 1.08 Data Analysis Software (BioTek). Analyses were carried out using GraphPad Prism 7.
In cellulo IPC synthase assay
The L. major Δlcb2 mutant24, maintained in Schneider’s media (Sigma-Aldrich) with 15% sera (ThermoFisher), were washed and 200 µl, at 1 × 107 ml−1, incubated in serum free media for 60 minutes at 26 °C before the addition of 10 µM of the compounds, in at least triplicate, and further incubation for 18 hours. Subsequently, the reaction was initiated by the addition of BODIPY FL C5-ceramide complexed to BSA (1.25 µl of 0.5 mM, ThermoFisher). Following further incubation at 26 °C for 1 hour, the lipids were extracted by phase separation in chloroform:methanol:water (10:10:3, 200 µl) and fractionated on HTPLC plates, as previously18. The fluorescence was read at Ex475/Em520 using a Fuji FLA-3000 plate reader and AIDA Image Analyser software (version 3.52).
References
Stuart, K. et al. Kinetoplastids: related protozoan pathogens, different diseases. J Clin Invest 118, 1301–1310, https://doi.org/10.1172/JCI33945 (2008).
Charlton, R. L., Rossi-Bergmann, B., Denny, P. W. & Steel, P. G. Repurposing as a strategy for the discovery of new anti-leishmanials: the-state-of-the-art. Parasitology, 1–18, https://doi.org/10.1017/S0031182017000993 (2017).
Croft, S. L. & Coombs, G. H. Leishmaniasis–current chemotherapy and recent advances in the search for novel drugs. Trends Parasitol 19, 502-508, doi:S1471492203002484 (2003).
Kedzierski, L. et al. Leishmaniasis: current treatment and prospects for new drugs and vaccines. Curr Med Chem 16, 599–614, https://doi.org/10.2174/092986709787458489 (2009).
Demicheli, C. et al. Oral delivery of meglumine antimoniate-beta-cyclodextrin complex for treatment of leishmaniasis. Antimicrob Agents Chemother 48, 100–103, https://doi.org/10.1128/AAC.48.1.100-103.2004 (2004).
Chappuis, F. et al. Visceral leishmaniasis: what are the needs for diagnosis, treatment and control? Nat Rev Microbiol 5, 873–882, https://doi.org/10.1038/nrmicro1748 (2007).
Croft, S. L., Sundar, S. & Fairlamb, A. H. Drug resistance in leishmaniasis. Clin Microbiol Rev 19, 111–126, https://doi.org/10.1128/CMR.19.1.111-126.2006 (2006).
Thakur, C. P. et al. Amphotericin B deoxycholate treatment of visceral leishmaniasis with newer modes of administration and precautions: a study of 938 cases. Trans R Soc Trop Med Hyg 93, 319–323 (1999).
Di Giorgio, C. et al. Flow cytometric assessment of amphotericin B susceptibility in Leishmania infantum isolates from patients with visceral leishmaniasis. J Antimicrob Chemother 44, 71–76 (1999).
Hendrickx, S., Guerin, P. J., Caljon, G., Croft, S. L. & Maes, L. Evaluating drug resistance in visceral leishmaniasis: the challenges. Parasitology, 1–11, https://doi.org/10.1017/S0031182016002031 (2016).
Bhattacharya, S. K. & Dash, A. P. Elimination of Kala-Azar from the Southeast Asia Region. Am J Trop Med Hyg, https://doi.org/10.4269/ajtmh.16-0279 (2017).
Denny, P. W. & Steel, P. G. Yeast as a potential vehicle for neglected tropical disease drug discovery. J Biomol Screen 20, 56–63, https://doi.org/10.1177/1087057114546552 (2015).
Norcliffe, J. L., Alvarez-Ruiz, E., Martin-Plaza, J. J., Steel, P. G. & Denny, P. W. The utility of yeast as a tool for cell-based, target-directed high-throughput screening. Parasitology 141, 8–16, https://doi.org/10.1017/S0031182013000425 (2014).
Pena, I. et al. New Compound Sets Identified from High Throughput Phenotypic Screening Against Three Kinetoplastid Parasites: An Open Resource. Scientific Reports 5, 8771, https://doi.org/10.1038/srep08771 (2015).
Mina, J. G. M. & Denny, P. W. Everybody needs sphingolipids, right! Mining for new drug targets in protozoan sphingolipid biosynthesis. Parasitology, 1–14, https://doi.org/10.1017/S0031182017001081 (2017).
Young, S. A., Mina, J. G., Denny, P. W. & Smith, T. K. Sphingolipid and ceramide homeostasis: potential therapeutic targets. Biochem Res Int 2012, 248135, https://doi.org/10.1155/2012/248135 (2012).
Georgopapadakou, N. H. Antifungals targeted to sphingolipid synthesis: focus on inositol phosphorylceramide synthase. Expert Opin Investig Drugs 9, 1787–1796, https://doi.org/10.1517/13543784.9.8.1787 (2000).
Denny, P. W., Shams-Eldin, H., Price, H. P., Smith, D. F. & Schwarz, R. T. The protozoan inositol phosphorylceramide synthase: A novel drug target which defines a new class of sphingolipid synthase. J Biol Chem 281, 28200–28209, https://doi.org/10.1074/jbc.M600796200 (2006).
Mina, J. G., Mosely, J. A., Ali, H. Z., Denny, P. W. & Steel, P. G. Exploring Leishmania major inositol phosphorylceramide synthase (LmjIPCS): insights into the ceramide binding domain. Org Biomol Chem 9, 1823–1830, https://doi.org/10.1039/c0ob00871k (2011).
Mina, J. G. et al. The Trypanosoma brucei sphingolipid synthase, an essential enzyme and drug target. Mol Biochem Parasitol 168, 16–23, https://doi.org/10.1016/j.molbiopara.2009.06.002 (2009).
Mandlik, V., Shinde, S., Chaudhary, A. & Singh, S. Biological network modeling identifies IPCS in Leishmania as a therapeutic target. Integr Biol (Camb) 4, 1130–1142, https://doi.org/10.1039/c2ib20037f (2012).
Mina, J. G. et al. A plate-based assay system for analyses and screening of the Leishmania major inositol phosphorylceramide synthase. Int J Biochem Cell Biol 42, 1553–1561, https://doi.org/10.1016/j.biocel.2010.06.008 (2010).
Nagiec, M. M. et al. Sphingolipid synthesis as a target for antifungal drugs. Complementation of the inositol phosphorylceramide synthase defect in a mutant strain of Saccharomyces cerevisiae by the AUR1 gene. J Biol Chem 272, 9809–9817, https://doi.org/10.1074/jbc.272.15.9809 (1997).
Denny, P. W., Goulding, D., Ferguson, M. A. & Smith, D. F. Sphingolipid-free Leishmania are defective in membrane trafficking, differentiation and infectivity. Mol Microbiol 52, 313–327, https://doi.org/10.1111/j.1365-2958.2003.03975.MMI3975 (2004).
Frame, I. J. et al. Yeast-based high-throughput screen identifies Plasmodium falciparum equilibrative nucleoside transporter 1 inhibitors that kill malaria parasites. ACS Chem Biol 10, 775–783, https://doi.org/10.1021/cb500981y (2015).
Bilsland, E. et al. Yeast-based automated high-throughput screens to identify anti-parasitic lead compounds. Open Biol 3, 120158, https://doi.org/10.1098/rsob.120158 (2013).
Wang, W. et al. An inositolphosphorylceramide synthase is involved in regulation of plant programmed cell death associated with defense in Arabidopsis. Plant Cell 20, 3163–3179, https://doi.org/10.1105/tpc.108.060053 (2008).
Cid, V. J., Alvarez, A. M., Santos, A. I., Nombela, C. & Sanchez, M. Yeast exo-beta-glucanases can be used as efficient and readily detectable reporter genes in Saccharomyces cerevisiae. Yeast 10, 747–756, https://doi.org/10.1002/yea.320100606 (1994).
Zhang, J. H., Chung, T. D. & Oldenburg, K. R. A simple statistical parameter for use in evaluation and validation of high throughput screening assays. J Biomol Screen 4, 67–73, https://doi.org/10.1177/108705719900400206 (1999).
Butina, D. Unsupervised data base clustering based on daylight’s fingerprint and tanimoto similarity: a fast and automated way to cluster small and large data set. s. J. Chem. Inf. Comput. Sci. 39, 747–750, https://doi.org/10.1021/ci9803381 (1999).
Young, R. J., Green, D. V., Luscombe, C. N. & Hill, A. P. Getting physical in drug discovery II: the impact of chromatographic hydrophobicity measurements and aromaticity. Drug Discov Today 16, 822–830, https://doi.org/10.1016/j.drudis.2011.06.001 (2011).
Patterson, S. & Wyllie, S. Nitro drugs for the treatment of trypanosomatid diseases: past, present, and future prospects. Trends Parasitol 30, 289–298, https://doi.org/10.1016/j.pt.2014.04.003 (2014).
Mandlik, V., Patil, S., Bopanna, R., Basu, S. & Singh, S. Biological activity of coumarin derivatives as anti-leishmanial agents. PLoS One 11, e0164585, https://doi.org/10.1371/journal.pone.0164585 (2016).
Mandlik, V. & Singh, S. Molecular docking and molecular dynamics simulation study of inositol phosphorylceramide synthase - inhibitor complex in leishmaniasis: Insight into the structure based drug design. F1000Res 5, 1610, https://doi.org/10.12688/f1000research.9151.2 (2016).
Escobar, P., Matu, S., Marques, C. & Croft, S. L. Sensitivities of Leishmania species to hexadecylphosphocholine (miltefosine), ET-18-OCH(3) (edelfosine) and amphotericin B. Acta Trop 81, 151–157, https://doi.org/10.1016/S0001-706×(01)00197-8 (2002).
De Rycker, M. et al. Comparison of a high-throughput high-content intracellular Leishmania donovani assay with an axenic amastigote assay. Antimicrob. Agents Chemother. 57, 2913–2922, https://doi.org/10.1128/AAC.02398-12 (2013).
Acknowledgements
Particular thanks to Prof Teresa Dunn, Uniformed Services University USA, for provision of the yeast strain used in this work. This work was supported by a Tres Cantos Open Lab Foundation Award to PWD and PGS. JLN was supported by the Open Lab Foundation and a Durham Doctoral Studentship. JGM was supported by the Open Lab Foundation and a Durham University Seedcorn Award. PWD is currently supported by grants from the Biotechnology and Biological Research Council (BB/M024156/1 and NPRONET); PWD and PGS are also supported by the Medical Research Council (MR/P027989/1). We thank Durham University’s Wolfson Research Institute for Health and Wellbeing, and Biophysical Sciences Institute for support.
Author information
Authors and Affiliations
Contributions
J.L.N. and J.G.M. constructed, validated and utilised the yeast assay; E.A., F. de D.-A. and G.C. managed all aspects of the screening process; S.G.-Del V., M.M. and J.M.F. oversaw project management; J.L.N., J.G.M. and J.C. analysed data and constructed figures; J.J.M., P.G.S and P.W.D. conceived, directly managed the project and analysed data; P.W.D. wrote the manuscript and constructed figures.
Corresponding authors
Ethics declarations
Competing Interests
The authors declare no competing interests.
Additional information
Publisher's note: Springer Nature remains neutral with regard to jurisdictional claims in published maps and institutional affiliations.
Electronic supplementary material
Rights and permissions
Open Access This article is licensed under a Creative Commons Attribution 4.0 International License, which permits use, sharing, adaptation, distribution and reproduction in any medium or format, as long as you give appropriate credit to the original author(s) and the source, provide a link to the Creative Commons license, and indicate if changes were made. The images or other third party material in this article are included in the article’s Creative Commons license, unless indicated otherwise in a credit line to the material. If material is not included in the article’s Creative Commons license and your intended use is not permitted by statutory regulation or exceeds the permitted use, you will need to obtain permission directly from the copyright holder. To view a copy of this license, visit http://creativecommons.org/licenses/by/4.0/.
About this article
Cite this article
Norcliffe, J.L., Mina, J.G., Alvarez, E. et al. Identifying inhibitors of the Leishmania inositol phosphorylceramide synthase with antiprotozoal activity using a yeast-based assay and ultra-high throughput screening platform. Sci Rep 8, 3938 (2018). https://doi.org/10.1038/s41598-018-22063-9
Received:
Accepted:
Published:
Version of record:
DOI: https://doi.org/10.1038/s41598-018-22063-9
This article is cited by
-
Identification of potential inhibitor against Leishmania donovani mitochondrial DNA primase through in-silico and in vitro drug repurposing approaches
Scientific Reports (2024)
-
The identification of small molecule inhibitors of the plant inositol phosphorylceramide synthase which demonstrate herbicidal activity
Scientific Reports (2019)